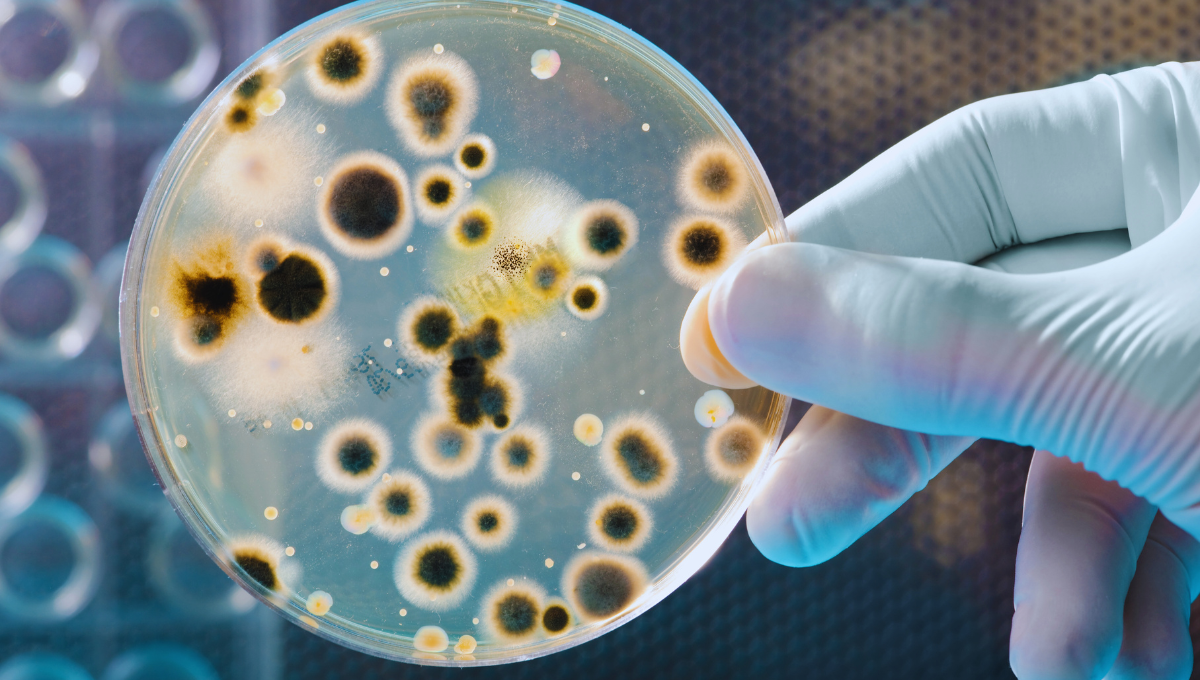

Secar los vasos boca abajo es una práctica común en muchos hogares y restaurantes. En ese sentido, una de las dudas más frecuentes es cómo secarlos de forma correcta luego de lavarlos en la bacha. Sin embargo, varios expertos en salud e higiene sugieren que esta costumbre puede no ser la mejor opción y estas son sus razones.
Razones por las que este hábito podría ser perjudicial
Durante mucho tiempo, se creyó que secar los vasos boca abajo era la forma más efectiva, ya que la gravedad haría que el agua se deslizara hacia abajo y el recipiente se secara más rápido. Sin embargo, esta visión fue desmentida por expertos en higiene.
Además, según estudios microbiológicos, las superficies húmedas son un caldo de cultivo para diversas bacterias, como la E. coli y el moho, que prosperan en ambientes cerrados y húmedos. Por ende, estas son las razones para nunca hacerlo:
►TE PUEDE INTERESAR: ¿Cúal es el significado espiritual de que exploten los vasos de repente?
- Acumulación de humedad y bacterias: Cuando los vasos se dejan secando boca abajo, el aire tiene dificultad para circular adecuadamente dentro del vaso. Esto puede provocar que la humedad se acumule en el fondo, creando un ambiente propicio para el crecimiento de bacterias y moho. Aunque los vasos pueden parecer secos por fuera, en su interior se pueden desarrollar microorganismos que luego terminan en las bebidas que consumimos.
- Olores desagradables: La falta de circulación de aire en el interior del vaso también puede llevar a la formación de olores desagradables. Estos olores no solo son molestos, sino que pueden alterar el sabor de las bebidas.
- Riesgo de rotura: Secar los vasos boca abajo, especialmente si se colocan con demasiada fuerza sobre superficies duras, puede aumentar el riesgo de que se agrieten o rompan. La presión que se ejerce sobre los bordes del vaso puede causar microfisuras que, aunque no visibles a simple vista, pueden debilitar el material con el tiempo.
- Mejor alternativa: boca arriba con buena ventilación: Para evitar los problemas mencionados, lo más recomendable es secar los vasos boca arriba en una superficie con buena ventilación. Colocarlos en un escurridor o sobre una toalla absorbente permite que el aire fluya libremente tanto dentro como fuera del vaso, acelerando el proceso de secado y evitando la acumulación de humedad.